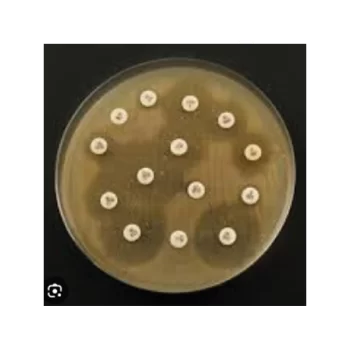

Showing 235–243 of 337 results
Oxoid™ Mupirocin Antibiogram Discs, 5 μg / Discos para antibiograma con mupirocina Oxoid™, 5 μg
S/ 0.00
[SKU: CT0523B]
Evalúe la sensibilidad de los microorganismos utilizando métodos AST manuales, con la ayuda de una amplia selección de discos para antibiogramas.
Oxoid™ Nalidixic Acid Antimicrobial Susceptibility discs / Discos de susceptibilidad antimicrobiana al ácido nalidíxico Oxoid™
S/ 0.00
[SKU: CT0031B]
Determine manualmente la susceptibilidad a los antibióticos de los microorganismos mediante métodos de prueba de susceptibilidad a los antimicrobianos (AST) junto con discos de susceptibilidad a los antimicrobianos del ácido nalidíxico Thermo Scientific™ Oxoid™, fiables y fáciles de usar.
Oxoid™ Neomycin Antibiogram Disks, 10 µg / Discos para antibiograma con nitrofurantoína Oxoid™, 200 μg
S/ 0.00
[SKU: CT0034B]
Evalúe la sensibilidad de los microorganismos utilizando métodos AST manuales, con la ayuda de una amplia selección de discos para antibiogramas.
Oxoid™ Neomycin Antibiogram Disks, 10 µg / Discos para antibiogramas con neomicina Oxoid™, 10 µg
S/ 0.00
[SKU: CT0032B]
Evalúe la sensibilidad de los microorganismos utilizando métodos AST manuales, con la ayuda de una amplia selección de discos para antibiogramas.
Oxoid™ Nitrofurantoin Antibiogram Discs, 200 μg / Discos para antibiograma con nitrofurantoína Oxoid™, 200 μg
S/ 0.00
[SKU: CT0069B]
Evalúe la sensibilidad de los microorganismos utilizando métodos AST manuales, con la ayuda de una amplia selección de discos para antibiogramas.
Oxoid™ Nitrofurantoin Antimicrobial Susceptibility discs / Discos de susceptibilidad antimicrobiana a nitrofurantoína Oxoid™
S/ 0.00
[SKU: CT0036B]
Determine manualmente la susceptibilidad a los antibióticos de los microorganismos mediante métodos de prueba de susceptibilidad a los antimicrobianos (AST) junto con discos de susceptibilidad a los antimicrobianos de nitrofurantoína Thermo Scientific™ Oxoid™ fiables y fáciles de usar.
Oxoid™ Norfloxacin Antimicrobial Susceptibility discs / Discos de susceptibilidad antimicrobiana a norfloxacina Oxoid™
S/ 0.00
[SKU: CT0434B]
Determine manualmente la susceptibilidad a los antibióticos de los microorganismos mediante métodos de prueba de susceptibilidad a los antimicrobianos (AST) junto con discos de susceptibilidad a los antimicrobianos de norfloxacina Thermo Scientific™ Oxoid™, confiables y fáciles de usar.
Oxoid™ Nystatin Antibiogram Discs, 100 Count / Discos para antibiogramas con nistatina Oxoid™, 100 unidades
S/ 0.00
[SKU: CT0073B]
Evalúe la sensibilidad de los microorganismos utilizando métodos AST manuales, con la ayuda de una amplia selección de discos para antibiogramas.
Oxoid™ Ofloxacin Antimicrobial Sensitivity Discs / Discos para sensibilidad antimicrobiana con ofloxacina Oxoid™
S/ 0.00
[SKU: CT0446B]
Evalúe la sensibilidad de los microorganismos utilizando métodos AST manuales, con la ayuda de una amplia selección de discos para antibiogramas.